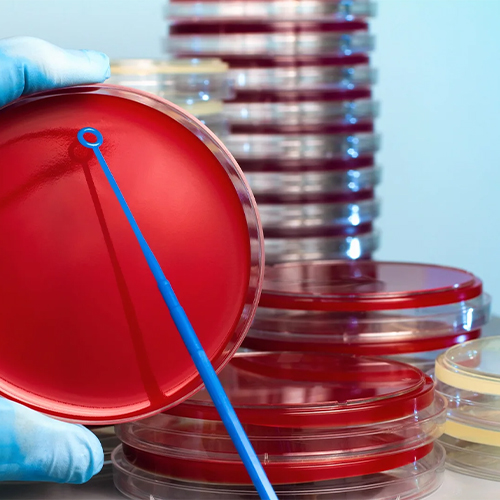

Culture Media
Prism Plates produce a broad variety of culturing media, from solid agar plates to liquids in tubes.
Explore More




Prism plates was founded in April 2019 and has manufactured 'custom-made' Ready Prepared Culture Media and Animal Blood Products to the highest possible standard ever since. With over 22 years of Microbiology Experience, we serve the Clinical-, Pharmaceutical-, Biotechnology-, Cosmetic-, Water-, Veterinarian-, Food- and Environmental Microbiology Testing- Laboratories. Our state -of -the- art Manufacturing facility located in holi city of Haridwar India. Every new enterprise has a fundamental purpose. Ours is driven by our passion for science and commitment to helping you accelerate innovation. From discovery to delivery, we are a trusted global partner to customers and suppliers in the life sciences and advanced technologies industries. By providing superior product and service solutions, we catalyze innovation and empower the success of our customers. Product range
Employes
Products
Happy Clients
At Prism Plates, our mission is to empower labs with high-quality microbiology testing solutions. With over 22 years of expertise, we deliver precision and innovation to support diverse industries, ensuring safety, quality, and compliance. We strive to exceed standards, building trust and lasting partnerships globally.
Prism Plates envisions becoming a global leader in microbiology testing, setting new standards in quality and innovation. We aim to empower labs worldwide with accuracy and efficiency, building enduring partnerships across industries. Our commitment to excellence and continuous improvement contributes to safer, healthier communities and trusted expertise.
Our team with proficiency and experience in their respective fields, persevere to rapidly altering demands of the microbial world. We have a fully automated facility for the production of sterilized media. We follow rigorous protocols and have supervised cleanrooms for the production of sterilized media.

Products Range.
We are Certified Manufacturer & Global Exporter of Ready to Use Media Plates. Blood Agar Plate, CLED Agar Plate, Chocolate Agar Plate, CCA Agar Plate ...
Read More
Culture media is a gel or liquid that contains nutrients and is used to grow bacteria or microorganisms. They are also termed growth media.
Read More
We have an entire range of lab consumables you need to achieve your goals and deliver breakthrough discoveries that save and improve lives.
Read More
Microbiological media is used to grow microorganisms in laboratory conditions. The growth media can be liquid or solid. In case of solid media, a gelling agent
Read MoreIf you have any questions or would like to request a personalised quotation, please get in touch with us, and we will get back to you as soon as possible.
Exceptional quality and reliability! Prism Plates' expertise and dedicated support make them our trusted partner for precise microbiology testing solutions.
More Testimonials"Prism Plates has been our go-to supplier for high-quality microbiology products. Their plates consistently perform well, delivering accurate and reproducible results every time. With over two decades of experience, they bring expertise we trust and depend on."

"We have partnered with Prism Plates for years, and their dedication to quality and reliability has been outstanding. The plates are always consistent, and their team truly understands the complexities of pharmaceutical testing. Prism Plates has been instrumental in helping us maintain our high standards."

"Prism Plates has transformed our microbiological testing process. Their knowledge and commitment to excellence show in every plate we receive. They go above and beyond to meet our specific biotech requirements, making them an invaluable partner."

"Working with Prism Plates has been a pleasure. Their expertise in the microbiology field ensures that our cosmetic testing is always reliable and efficient. The team is professional, responsive, and understands the nuances of our industry, making our job so much easier."

© www.prismplates.com. All Rights Reserved.
Designed by Abtus World